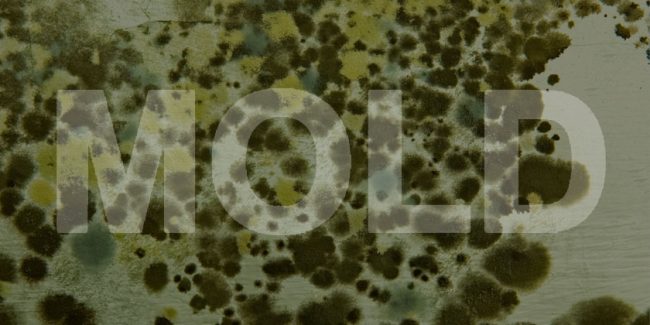

Mold Remediation Costs 2022
Cost Of Mold Remediation Professional mold remediation costs an average of $2,215 in the U.S. in 2021. Prices for this project will range from $1,121-$3,331, according to HomeAdvisor. Average Mold Remediation Costs All larger remediation projects should be handled by the professionals. However, small removal projects (typically under 10 square feet) can be handled as…